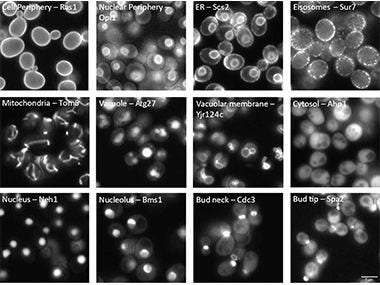
Yeast Protein Localization Classified Using TruAI™ Deep-Learning Technology

Tecnología TruAI Análisis de imágenes precisos y eficientes por microscopía de aprendizaje profundo (Deep Learning)
TruAI es un análisis de imágenes eficiente y preciso basado en la tecnología de aprendizaje profundo. Conozca más acerca de este producto.

Segmentación de imagen
Rapidez y eficiencia
- Detección y segmentación de alta precisión basada en la tecnología de aprendizaje profundo (Deep Learning) para ofrecer resultados analíticos eficaces y confiables.
- Idoneidad para el recuento de células y mediciones geométricas, como del área o la forma, sin fototoxicidad.
- Menos de un segundo de procesamiento por posición
Consulte el informe técnico sobre la tecnología TruAI

Ejemplo que muestra la detección de núcleos. Esquema que muestra la aplicación (inferencia) de la red neural formada.
Análisis de imágenes de vanguardia basado en el aprendizaje profundo
En los experimentos siempre se requieren datos que procedan de las imágenes microscópicas. Para un análisis más preciso de imágenes, la segmentación —en especial los umbrales basados en los valores o colores de intensidad— se usa para extraer objetivos analíticos de la imagen. Sin embargo, esto necesita bastante dedicación y puede tener efectos en la condición de la muestra.
El análisis de imágenes de última generación de la tecnología TruAI ayuda a afrontar estos desafíos.


Solo se detectan las células en división (der.)
Previsión de células mitóticas usando la tecnología TruAI (verde).


Tecnología TruAI al detectar las características de los glomérulos (derecha).
Previsión de la posición de glomérulos en una sección de riñón de un ratón con TruAI (azul).


En verde: Imagen de fluorescencia de los núcleos. En azul: Núcleos detectados de la imagen de campo brillante por la tecnología TruAI
Verde: Se percibe una precisión de detección baja debido a la irregularidad del marcado GFP.
Azul: Detección de núcleos con alta precisión a pesar de los rasguños y el polvo en el recipiente.
Optimización de la imagen
La red neuronal puede aprender de antemano las características del ruido, lo que permite construir imágenes con una óptima relación señal-ruido, aunque las señales sean débiles.
Las imágenes ruidosas con una intensidad de fluorescencia muy débil también dificultan el reconocimiento de objetos en la segmentación. Por otro parte, es importante minimizar el desvanecimiento de las imágenes y adquirirlas lo antes posible.
La eliminación del ruido mediante la tecnología de aprendizaje profundo permite obtener imágenes nítidas cuando el nivel de ruido es alto y el tiempo de exposición es corto.


Ganerate clear image with high signal-to-noise ratio from noisy image
Button
Ahorre tiempo y esfuerzo gracias a la inteligencia artificial (IA) en vivo
Observe cómo se manifiestan en tiempo real los resultados de inferencia a partir de la red neuronal formada. El hecho de conocer los resultados de inferencia antes de comenzar la adquisición de imágenes aumenta la eficiencia de sus experimentos.
https://adobeassets.evidentscientific.com/content/dam/video/video/library/TruAI_lp.mp4
Detección en vivo de las diferentes fases de un ciclo celular a partir de un cultivo de células HeLa*
Naranja: fase G1. Verde: fase S y G2. Rojo: núcleos mitótico e «hija»
*Si bien estas líneas celulares forman parte de las más importantes para la investigación médica, es imperativo reconocer la contribución de Henrietta Lacks a la ciencia que se produjo sin su consentimiento. Esta injusticia, a pesar de haber dado lugar a descubrimientos clave en inmunología, enfermedades infecciosas y cáncer, también ha generado importantes debates sobre la privacidad, la ética y el consentimiento en la medicina.
Para obtener más información sobre la vida de Henrietta Lacks y su contribución a la medicina moderna, haga clic aquí.
http://henriettalacksfoundation.org/
Procesamiento de imágenes macro a micro
La función de nivel macro a micro permite adquirir una imagen sinóptica por medio de objetivos de baja magnificación, como de 4x; a continuación, detecta el área de la muestra y adquiere las imágenes a partir de ella con alta magnificación. Gracias a la tecnología TruAI, este proceso se ejecuta de forma automática y conlleva a un procesamiento de imágenes más rápido y eficiente cuando se usan portaobjetos de vidrio o placas con múltiples secciones de tejido.


«El reconocimiento de los núcleos preteñidos es absolutamente increíble; ahora, es posible analizar fácilmente muestras muy heterogéneas sin comprometer las fracciones celulares. En particular, cuando se trata de áreas de alta densidad celular, la separación basada en la tecnología TruAI es claramente superior a la intensidad o la detección de bordes, tanto a nivel de la velocidad como del rendimiento».
Robert Strauss
Científico superior
Centro de Investigación de la Sociedad Danesa de Oncología [Danish Cancer Society]
Más información
Productos relacionados

APX100
- Sistema microscópico todo en uno fácil de usar
- Imágenes de calidad para publicación en unos pocos clics
- Gestión de datos rápida y eficiente

IXplore SpinSR
- Superresolución de hasta 120nm en XY
- Viabilidad celular prolongada en imágenes confocales de intervalos gracias a la reducción de la fototoxicidad y el fotoblanqueo
- Alternación posible en un clic entre los modos de campo amplio, confocal y de superresolución
- Reproducción 3D precisa con los objetivos de inmersión en aceite de silicona de Olympus

FV4000
- Rango dinámico revolucionario para el procesamiento de imágenes desde la macroescala hasta las estructuras subcelulares.
- Multiplexación de hasta seis canales simultáneamente con la tecnología TruSpectral
- Rediseño de los escáneres con alta velocidad y resolución para el procesamiento de imágenes fijas y de células vivas
- Optimización de la profundidad y la fotosensibilidad con funciones innovadoras del infrarrojo cercano (NIR) y óptica de renombre
- Tranquilidad gracias al detector fiable y de disparo repetible SilVIR.
- Diez líneas de láser líderes de la industria * con un rango espectral más amplio de 405 nm a 785 nm
*Desde octubre de 2023.

FV4000MPE
- Adquiera datos de imágenes precisas y cuantitativas desde la macroescala hasta las estructuras subcelulares
- Obtenga más información a partir de una sola imagen multicolor
- Monitorice neuronas y otras dinámicas esenciales con un procesamiento de imágenes de alta velocidad

SLIDEVIEW VS200
Combinando imágenes multiplexadas de alta calidad, reproducción cromática precisa en campo claro, claridad óptica en muestras gruesas y la más amplia gama de modalidades de imagen en un solo escáner de portaobjetos, el sistema SLIDEVIEW™ VS200 permite a los investigadores capturar datos más significativos de cada muestra, sin complejidad, intervención manual ni necesidad de múltiples instrumentos. Diseñado para ofrecer resultados consistentes y repetibles para distintos usuarios y flujos de trabajo, el sistema VS200 le ayuda a obtener más conocimientos de sus portaobjetos mientras apoya necesidades de imagen escalables.

scanR
- Análisis y adquisición de imágenes de forma rápida y precisa
- Control de experimentos hiperpreciso en tiempo real
- Módulo de análisis